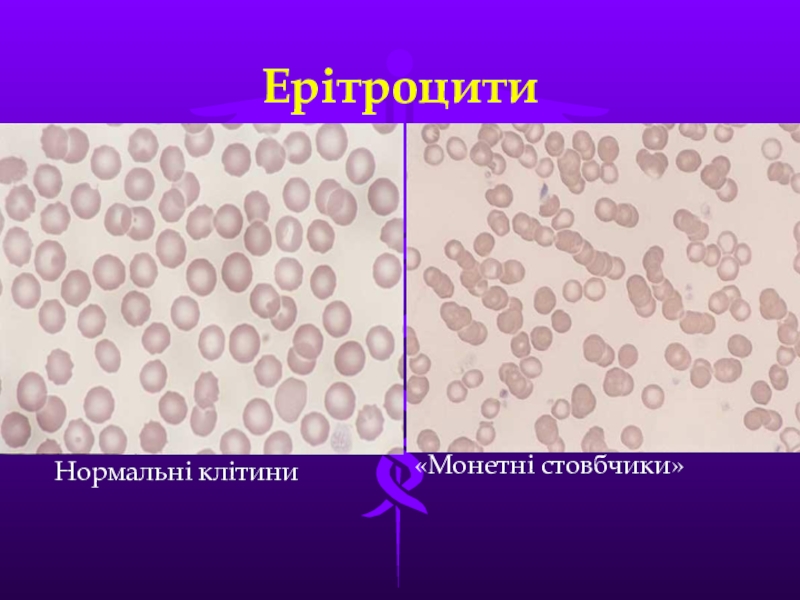
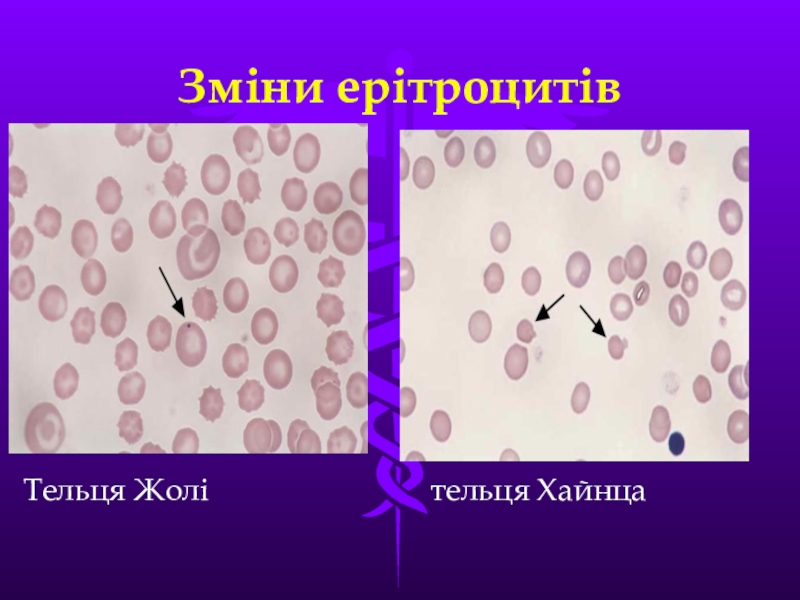
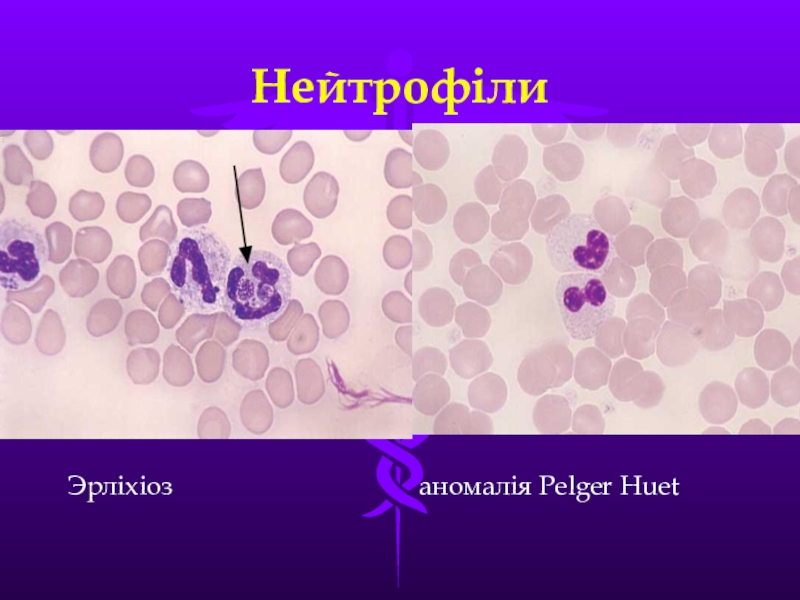

- Главная
- Разное
- Образование
- Спорт
- Естествознание
- Природоведение
- Религиоведение
- Французский язык
- Черчение
- Английский язык
- Астрономия
- Алгебра
- Биология
- География
- Геометрия
- Детские презентации
- Информатика
- История
- Литература
- Математика
- Музыка
- МХК
- Немецкий язык
- ОБЖ
- Обществознание
- Окружающий мир
- Педагогика
- Русский язык
- Технология
- Физика
- Философия
- Химия
- Шаблоны, фоны, картинки для презентаций
- Экология
- Экономика
Презентация, доклад на тему Клетки крови
Содержание
- 1. Клетки крови
- 2. Взяття крові у тварин Невелику кількість
- 3. Велику кількість крові у великих тварин (коні,
- 4. Відбір крові Артефакти
- 5. Підрахунок еритроцитів пробірковим методом М.П.П’ятницького Посуд,
- 6. Кількість еритроцитів
- 7. Ерітроцити Нормальні клітини«Монетні стовбчики»
- 8. Патології еритроцитівРегенеративна анемія анізо- пойкилоцитоз
- 9. Зміни ерітроцитівМегалобластич. анемія Бабезіоз
- 10. Зміни ерітроцитів Хрон. геморагія
- 11. Зміни ерітроцитівТельця Жолі
- 12. Підрахунок лейкоцитів за методом П’ятницького Обладнання:
- 13. Кількість лейкоцитів
- 14. Лейкограма Визначення загальної кількості лейкоцитів не дає
- 15. Лейкограма крові тварин
- 16. Нейтрофіли Генез
- 17. Нейтрофіли Юні
- 18. НейтрофілиТоксичні клітини
- 19. НейтрофілиЭрліхіоз
- 20. Еозінофіли Нормальні
- 21. Базофіли Норма Лейкемія
- 22. Моноцити Норма
- 23. Лімфоцити у нормі
- 24. Лімфоцити Плазм. клітини атипічні
- 25. Уніфікований метод підрахунку тромбоцитів в камері Принцип. Підрахунок
- 26. Розводять досліджувальну кров в 200 раз; для
- 27. Тромбоцити
- 28. Тромбоцити Норма зклеєні
- 29. Узагальнена таблиця
- 30. Дякую за увагу!
Взяття крові у тварин Невелику кількість крові, необхідну для морфологічного дослідження, у тварин можна отримати із вен вушної раковини. Перед взяттям крові місце проколу простригають, дезінфікують спиртом або ефіром. Вену пережимають ближче до основи вушної
Слайд 2
Взяття крові у тварин
Невелику кількість крові, необхідну для морфологічного дослідження, у
тварин можна отримати із вен вушної раковини. Перед взяттям крові місце проколу простригають, дезінфікують спиртом або ефіром. Вену пережимають ближче до основи вушної раковини, потім проколюють її під прямим кутом стерильною ін’єкційною голкою. Для створення твердої основи вухо з протилежної сторони підтримують пальцем з накладеним на нього ватним тампоном. Для діагностики піроплазмідозів, мазки готують із першої краплі крові, яка з’явилася із судини. При малому витіканні кров видавлювати не можна. У курей кров отримують із гребеня або сережки, у гусей і качок – із м’якоті ступні кінцівок, у хутрових звірів – з м’якуша пальця.
Слайд 3 Велику кількість крові у великих тварин (коні, велика і дрібна рогата
худоба, свині, верблюди) беруть із яремної вени. У свиней, крім цього, кров можна взяти із великих судин вуха, орбіти або із хвостової вени, для чого кінчик хвоста вистригають, а потім гострим скальпелем роблять надріз його вентральної поверхні. У собак та інших м’ясоїдних кров отримують з судин кінцівок, у кролів – із вушної, у птахів – з підкрилової вени. Для попередження гемолізу кров має поступати в пробірку по стінці.
Слайд 5
Підрахунок еритроцитів пробірковим методом М.П.П’ятницького
Посуд, обладнання: скляні піпетки об’ємом 5 мл
або автоматичні дозатори; капілярні піпетки об’ємом 0,02 мл; пробірки Флоринського з пробками (короткі) або флакони з під антибіотиків.
Реактиви: 3 %-ий розчин натрію хлориду.
Хід виконання. Відмірюють у флакон або пробірку 3,98 мл 3 %-го розчину натрію хлориду. Капілярною піпеткою набирають 0,02 мл крові і вносять у розчин натрію хлориду. Флакони закривають пробками і суміш перемішують. Одержують розведення 1:200. Заряджають лічильну камеру і ведуть підрахунок клітин так само, як і при розведенні крові меланжерним методом.
При підрахунку клітин у цільній крові капіляр та піпетки на 0,02 мл необхідно промити антикоагулянтом.
Реактиви: 3 %-ий розчин натрію хлориду.
Хід виконання. Відмірюють у флакон або пробірку 3,98 мл 3 %-го розчину натрію хлориду. Капілярною піпеткою набирають 0,02 мл крові і вносять у розчин натрію хлориду. Флакони закривають пробками і суміш перемішують. Одержують розведення 1:200. Заряджають лічильну камеру і ведуть підрахунок клітин так само, як і при розведенні крові меланжерним методом.
При підрахунку клітин у цільній крові капіляр та піпетки на 0,02 мл необхідно промити антикоагулянтом.
Слайд 12
Підрахунок лейкоцитів за методом П’ятницького
Обладнання: скляні піпетки П’ятницього на 0,38 мл
або автоматичні дозатори об’ємом 1 мл (200–1000,0), капіляри об’ємом 0,02 мл, лічильні камери з сіткою Горяєва, мікроскоп, пробірки Флоринського або флакони з-під антибіотиків.
Реактиви: рідина Тюрка.
Хід роботи. У пробірки Флоринського або флакони піпеткою вносять 0,38 мл розчину Тюрка, добавляють 0,02 мл крові. Отримують розведення у 20 разів. Перемішують і заправляють лічильну камеру. Підрахунок лейкоцитів ведуть так само, як і при використанні меланжерного методу. Кількість лейкоцитів вираховують за такою самою формулою.
Реактиви: рідина Тюрка.
Хід роботи. У пробірки Флоринського або флакони піпеткою вносять 0,38 мл розчину Тюрка, добавляють 0,02 мл крові. Отримують розведення у 20 разів. Перемішують і заправляють лічильну камеру. Підрахунок лейкоцитів ведуть так само, як і при використанні меланжерного методу. Кількість лейкоцитів вираховують за такою самою формулою.
Слайд 14Лейкограма
Визначення загальної кількості лейкоцитів не дає уявлення про кількість окремих видів
лейкоцитів. Такі дані можна отримати при дослідженні лейкограми – відсоткового співвідношення окремих форм лейкоцитів.
Лейкограму визначають у забарвлених мазках периферичної крові диференційованим підрахунком 100 або 200 клітин за методами Меандра або Філіпченка. Підрахунок проводять при великому збільшенні мікроскопа під імерсійним об`єктивом. За методом Філіпченка підрахунок клітин ведеться на початку, посередині та в кінці мазка або тільки посередині від одного краю до протилежного. За методом Меандра клітини рахують у чотирьох місцях мазка.
Знаючи загальну кількість лейкоцитів та лейкограму, можна визначити абсолютну кількість клітин кожного виду в 1 мкл крові і вияснити характер лейкоцитозу чи лейкопенії – відносні вони чи абсолютні.
Лейкограму визначають у забарвлених мазках периферичної крові диференційованим підрахунком 100 або 200 клітин за методами Меандра або Філіпченка. Підрахунок проводять при великому збільшенні мікроскопа під імерсійним об`єктивом. За методом Філіпченка підрахунок клітин ведеться на початку, посередині та в кінці мазка або тільки посередині від одного краю до протилежного. За методом Меандра клітини рахують у чотирьох місцях мазка.
Знаючи загальну кількість лейкоцитів та лейкограму, можна визначити абсолютну кількість клітин кожного виду в 1 мкл крові і вияснити характер лейкоцитозу чи лейкопенії – відносні вони чи абсолютні.
Слайд 25Уніфікований метод підрахунку тромбоцитів в камері
Принцип. Підрахунок тромбоцитів в 1 мкл
(або 1 л) з урахуванням розведення крові і об’єму квадрата лічильної сітки із застосуванням фазово-контрастного приладу для контрастування тромбоцитів.
Реактиви: Застосовують реактив 1 або 2.
1.Кокаїн гідрохлорид – 3 г, натрій хлорид – 0,25 г, фурацилін – 0,025 г, дистильована вода – 10 мл.
2.1% розчин оксалата амонію. Розчин кип’ятять і фільтрують. Зберігають в холодильнику. Порівнювальний аналіз дозволив рахувати кращим 1% розчин оксалата амонію, так як він дає швидкий і повний лізис еритроцитів.
Реактиви: Застосовують реактив 1 або 2.
1.Кокаїн гідрохлорид – 3 г, натрій хлорид – 0,25 г, фурацилін – 0,025 г, дистильована вода – 10 мл.
2.1% розчин оксалата амонію. Розчин кип’ятять і фільтрують. Зберігають в холодильнику. Порівнювальний аналіз дозволив рахувати кращим 1% розчин оксалата амонію, так як він дає швидкий і повний лізис еритроцитів.
Слайд 26 Розводять досліджувальну кров в 200 раз; для цього в суху пробірку
набирають 4 мл реактиву 1 або 2 і 0,02 мл крові.
Переміщують і залишають на 25-30 хв. для гемолізу еритроцитів. Готують лічильну камеру. Переміщують розведену кров і заповнюють камеру; підносять краплю її за допомогою скляної палочки або пастерівської піпетки до краю покривного скла, слідкуючи за тим, щоб кров рівномірно без пухирців повітря заповняла всю поверхню сітки, не затікаючи в рівчики. Кладуть лічильну камеру у вологу камеру на 5 хвилин для осідання тромбоцитів (чашка Петрі з викладеним по краях, змоченою водою, фільтрувальним папером. Готують фазово-контрастний прилад в відповідності з інструкцією.
Проводять підрахунок тромбоцитів в 25 великих квадратах.
Тромбоцити виглядають в лічильній камері у вигляді дрібних утворень.
Розрахунок числа тромбоцитів проводять, виходячи із розведення крові, числа порахованих квадратів (25) і об’єму одного великого квадрата ( мкл, так як сторона квадрата мм, висота мм).
Х – число тромбоцитів в 1 мкл крові;
а – число тромбоцитів, порахованих в 25 великих квадратах.
Практично число підрахованих тромбоцитів множать на 2000.
Переміщують і залишають на 25-30 хв. для гемолізу еритроцитів. Готують лічильну камеру. Переміщують розведену кров і заповнюють камеру; підносять краплю її за допомогою скляної палочки або пастерівської піпетки до краю покривного скла, слідкуючи за тим, щоб кров рівномірно без пухирців повітря заповняла всю поверхню сітки, не затікаючи в рівчики. Кладуть лічильну камеру у вологу камеру на 5 хвилин для осідання тромбоцитів (чашка Петрі з викладеним по краях, змоченою водою, фільтрувальним папером. Готують фазово-контрастний прилад в відповідності з інструкцією.
Проводять підрахунок тромбоцитів в 25 великих квадратах.
Тромбоцити виглядають в лічильній камері у вигляді дрібних утворень.
Розрахунок числа тромбоцитів проводять, виходячи із розведення крові, числа порахованих квадратів (25) і об’єму одного великого квадрата ( мкл, так як сторона квадрата мм, висота мм).
Х – число тромбоцитів в 1 мкл крові;
а – число тромбоцитів, порахованих в 25 великих квадратах.
Практично число підрахованих тромбоцитів множать на 2000.